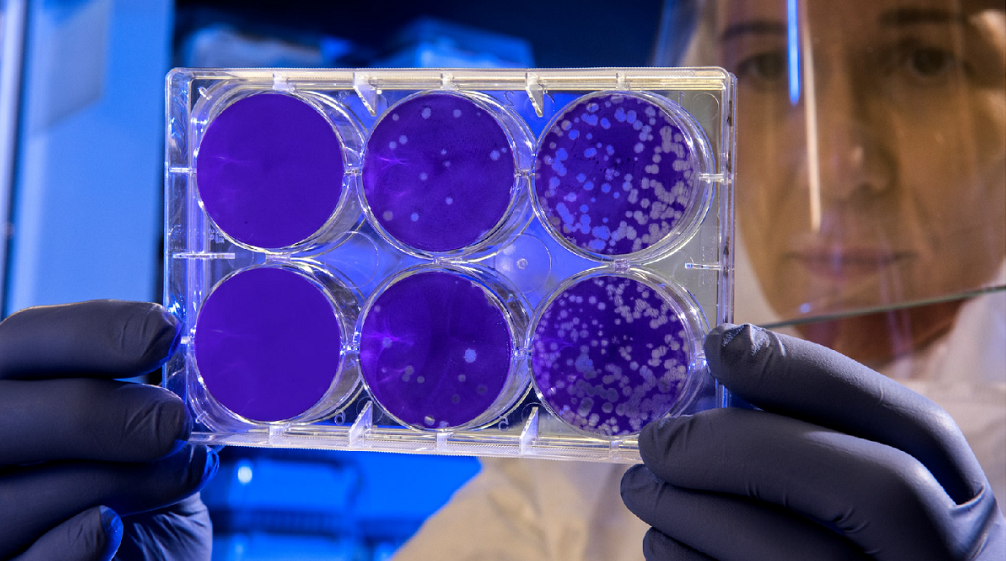

Fonte: Yale Climate Connections - 22.02.2023
Ondate di calore, inondazioni, siccità e temperature in aumento alimentate dai cambiamenti climatici hanno reso il mondo più vulnerabile alle epidemie e alla diffusione di un'ampia varietà di agenti patogeni, da batteri e virus a funghi e protozoi.
I cambiamenti climatici fanno aumentare la diffusione delle malattie infettive in tutto il mondo
Secondo un'analisi pubblicata sulla rivista «Nature Climate Change», il cambiamento climatico ha già aumentato di quasi il 60% il rischio di contrarre tutte le malattie infettive conosciute, comprese le malattie trasmesse da zecche e zanzare – come la malattia di Lyme e la dengue – e varie infezioni trasmesse da cibo e acqua.
I rischi aumenteranno man mano che le estati diventano più lunghe e più calde, gli inverni più brevi e più miti e gli eventi meteorologici in tutto il mondo più estremi e imprevedibili. I crescenti rischi di malattie infettive che prosperano in questi ambienti proverranno non solo da agenti patogeni noti, affermano gli esperti: è anche più probabile che emergano nuove malattie infettive.
«I focolai di malattie infettive emergenti e riemergenti sono in continua accelerazione», afferma Syra Madad, epidemiologa di malattie infettive e direttrice senior del programma agenti patogeni speciali a livello di sistema presso New York City Health + Hospitals.
Anni di aggressione globale da parte del COVID, combinati con sconvolgimenti climatici sempre più gravi, hanno dato alla popolazione di tutto il mondo un'anteprima di ciò che potrebbe portare un futuro di cambiamenti climatici ininterrotti.
Per promuovere una salute migliore, gli individui e la società dovranno destreggiarsi tra la vigilanza immediata e le misure a lungo termine, come la riduzione drastica dell'inquinamento da carbonio e del degrado ambientale, destinando al contempo maggiori risorse all'educazione delle persone sui rischi degli agenti patogeni locali e sui benefici di una migliore alimentazione, dell'igiene e dell'aggiornamento sui vaccini.
Febbre da clima
Il cambiamento climatico sta creando maggiori occasioni di esposizione avvicinando l'uomo e gli agenti patogeni e selezionando al contempo gli agenti patogeni che si evolvono per sopravvivere a temperature più elevate.
Alcune infezioni si diffondono attraverso la trasmissione vettoriale, cioè attraverso la puntura di zanzare, zecche, pulci e altri organismi. Temperature più calde in aree geografiche più vaste, inverni più brevi e primavere più precoci incoraggiano le persone a trascorrere del tempo all'aperto e permettono a questi vettori di prendere piede in un territorio più vasto. Ciò comporta un aumento del rischio di esposizione a malattie come la malattia di Lyme, il virus del Nilo occidentale e l'ehrlichiosi. Secondo il CDC [1], tra il 2004 e il 2018 il numero di malattie segnalate negli Stati Uniti a causa di punture di pulci, zanzare e zecche è raddoppiato.
Le temperature più elevate e l'aumento delle attività ricreative in prossimità dell'acqua avvicinano un maggior numero di persone alla fonte di infezioni trasmesse dall'acqua, che possono causare malattie come diarrea, infezioni intestinali e, in casi rari e più gravi, infezioni come la meningoencefalite amebica primaria, causata da un'ameba che può trovare rifugio in acque dolci e calde come laghi e fiumi.
L'aumento delle temperature aumenta anche il rischio che le malattie infettive si evolvano tollerando e prosperando in ambienti più caldi. Ciò rende più difficile per gli esseri umani combattere le infezioni attraverso uno dei migliori meccanismi di difesa contro le infezioni invasive: l'aumento della febbre. Gli agenti patogeni che sviluppano una maggiore capacità di superare questa difesa saranno sempre più pericolosi.
Oltre ai rischi legati alla diffusione e all'aumento della virulenza – o forza – delle malattie infettive note, stiamo vivendo in un'epoca con maggiori rischi di esposizione a infezioni completamente nuove.
«La nostra impronta ecologica si sta espandendo e gli eventi di spillover stanno aumentando», afferma Madad. Gli eventi di spillover sono quelli in cui un agente patogeno salta da un ospite originario a una nuova specie, come è successo con la MERS, o sindrome respiratoria del Medio Oriente, da parte di un virus segnalato per la prima volta nell'uomo nel 2012. Un evento di spillover è anche una probabile spiegazione dell'origine del virus che causa il COVID-19, che ricorda da vicino i virus che circolano tra i pipistrelli.
La pericolosità di una malattia infettiva per un ospite dipende da molti fattori, ma il primo è la capacità del patogeno di infettare effettivamente una cellula ospite. Man mano che gli esseri umani invadono sempre di più gli habitat naturali della fauna selvatica, nuovi agenti patogeni hanno l'opportunità di sviluppare le mutazioni giuste per passare da un ospite animale e infettare un ospite umano. Con ulteriori opportunità, possono emergere altre mutazioni che alla fine consentono il trasferimento da uomo a uomo di un agente patogeno completamente nuovo. La combinazione di cambiamenti climatici che costringono la fauna selvatica a lasciare i propri habitat e l'espansione dell'impronta umana negli habitat della fauna selvatica non farà che aumentare i rischi di nuove infezioni negli eventi di spillover.
Aumento della vulnerabilità umana
Anche le vulnerabilità umane influiscono sulla capacità di un agente patogeno di causare malattie. In generale, l'infezione da parte di un agente patogeno completamente nuovo, cioè senza esposizione precedente, significa che una persona non ha alcuna protezione immunitaria da un'infezione precedente (anche se ci sono alcune eccezioni, poiché l'esposizione a una famiglia di virus simili può conferire una certa immunità incrociata).
Anche altri fattori giocano un ruolo nella suscettibilità di base. Ad esempio, una malattia cronica preesistente o la fragilità dovuta all'età estrema possono alterare notevolmente la gravità di una determinata malattia infettiva. Anche i cambiamenti climatici possono esacerbare questi problemi: gli eventi meteorologici estremi possono provocare sfollamenti, la siccità può portare all'insicurezza alimentare e gli incendi possono peggiorare la qualità dell'aria. Tutti questi fattori possono rendere le persone più vulnerabili a infezioni più gravi. E come nel caso del COVID e di altri problemi globali, gli impatti dei cambiamenti climatici spesso colpiscono più duramente le persone già emarginate o più vulnerabili.
James Ford, ricercatore sull'adattamento ai cambiamenti climatici e professore presso il Priestley International Centre for Climate dell'Università di Leeds, ha studiato come le vulnerabilità combinate ai cambiamenti climatici e al COVID-19 si manifestino tra le popolazioni indigene di dodici nazioni, tra cui quelle dell'Artico, del Perù, dell'India e di alcune zone dell'Africa.
Ford ha detto che la sua ricerca suggerisce che i precedenti disastri climatici hanno avuto conseguenze per la gestione del COVID, a causa della distruzione delle postazioni sanitarie e di altre infrastrutture critiche necessarie per servire le comunità locali.
Gli eventi climatici possono anche compromettere la capacità di una comunità di rispondere alle minacce di malattie infettive con le normali misure di protezione della salute pubblica. Ad esempio, eventi meteorologici estremi possono affollare le persone in aree di rifugio non sicure, dove è impossibile mantenere la distanza sociale. Inoltre, le ondate di calore possono rendere meno desiderabile trascorrere del tempo all'aperto o indossare maschere in casa per rimanere al sicuro dalle malattie infettive trasmesse per via aerea.
Cosa possono fare le persone?
L'esperienza mondiale nella risposta ai disastri COVID e climatici fornisce una guida per le strategie che possono proteggere la salute.
Le contromisure che riducono l'esposizione alle crescenti minacce climatiche e alle malattie infettive, sia a breve che a lungo termine, sono fondamentali. Esse includono la riduzione dell'inquinamento da carbonio, la minimizzazione del degrado ambientale e dei cambiamenti nell'uso del suolo e l'incoraggiamento dell'educazione pubblica sui rischi locali di vari agenti patogeni. I singoli e le comunità possono anche intraprendere azioni come tenersi aggiornati con i vaccini, ottimizzare la salute con un'alimentazione di alta qualità e garantire l'accesso ai servizi sanitari nel caso in cui una malattia infettiva si radichi in una comunità.
«Anche per le comunità più emarginate questa può essere una storia di resilienza e di vulnerabilità», afferma Ford.
Nota
[1] CDC, acronimo per Centers for Disease Control and Prevention. Si tratta di un «importante organismo di controllo sulla sanità pubblica degli Stati Uniti d'America. Il CDC è un'agenzia federale degli Stati Uniti, facente parte del Dipartimento della salute e dei servizi umani ed ha la sede principale ad Atlanta, Georgia. Il suo obiettivo principale è proteggere la salute e la sicurezza pubblica attraverso il controllo e la prevenzione di malattie, infortuni e disabilità negli Stati Uniti e nel mondo. Il CDC si concentra principalmente su malattie infettive, intossicazioni alimentari, benessere ambientale, salute e sicurezza sul lavoro, promozione della salute, prevenzione degli infortuni e su attività educative aventi lo scopo di migliorare il benessere dei cittadini statunitensi. Insieme alla FDA (Food and Drug Administration) monitora la sicurezza dei vaccini». [da Wikipedia]
Neha Pathak
Traduzione di Alessandro Cocuzza - Redazione di Antropocene.org
Fonte: Climate&Capitalism 22.02.2023